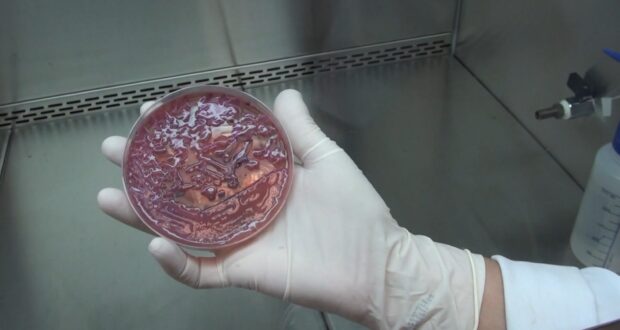

O Hospital Estadual Sumaré (SP) comunicou nesta quinta-feira (16) a identificação da bactéria multirresistente KPC em 14 pacientes que estavam internados na unidade. A detecção ocorreu por meio de exames de rotina e, conforme esclarecido pela instituição, essa presença não se configura como uma infecção ativa, mas sim como colonização.
A colonização pela KPC significa que a superbactéria reside no organismo sem provocar doenças ou sintomas, não havendo, portanto, necessidade de tratamento com antibióticos. O hospital enfatizou que se tratam de casos antigos e que nenhum dos pacientes apresenta um quadro infeccioso ativo, mas a unidade adotou medidas preventivas rigorosas para garantir a segurança de todos.
KPC: A Superbactéria e Sua Origem no Ambiente Hospitalar
A KPC, ou *Klebsiella pneumoniae carbapenemase*, é amplamente conhecida como uma 'superbactéria' devido à sua capacidade de resistir a diversos antibióticos, incluindo os de última geração. Ela age produzindo uma enzima que inativa uma ampla gama de medicamentos tradicionalmente utilizados no combate a infecções bacterianas. Identificada no Brasil no início dos anos 2000, a KPC tem sido responsável por surtos periódicos em unidades de saúde em todo o país.
Conforme explica o infectologista e professor da Unicamp, Plínio Trabasso, o surgimento e a prevalência de bactérias multirresistentes como a KPC são uma consequência direta do uso prolongado e intenso de antibióticos potentes no ambiente hospitalar. Essa pressão seletiva favorece o desenvolvimento e a proliferação de cepas que se tornam resistentes aos tratamentos existentes, tornando o controle de sua disseminação um desafio fundamental na saúde pública.
Ações Preventivas no Hospital de Sumaré Diante da Colonização
Mesmo sem um quadro infeccioso ativo, o Hospital Estadual de Sumaré mantém um elevado nível de alerta e implementou uma série de protocolos preventivos. Entre as medidas estão o isolamento dos pacientes identificados, sinalização específica para as áreas envolvidas e o uso de equipamentos exclusivos para evitar qualquer possibilidade de transmissão. Além disso, a equipe assistencial segue a obrigatoriedade de uso de Equipamentos de Proteção Individual (EPIs), e há uma intensificação dos processos de limpeza e desinfecção em todas as dependências.
A instituição também reforçou seu compromisso com a segurança e a qualidade do atendimento, garantindo o fornecimento contínuo de insumos necessários e a capacitação constante de suas equipes para o manejo de situações envolvendo patógenos multirresistentes.
KPC no Contexto Regional: Desafios e Nuances de um Agente Infeccioso
A identificação de superbactérias como a KPC em ambientes hospitalares não é um evento isolado na região. Anteriormente, Campinas registrou casos semelhantes, como a identificação da KPC em sete pacientes no Hospital Municipal Dr. Mário Gatti, que levou ao fechamento temporário de uma UTI. É importante destacar que, embora a presença da bactéria exija vigilância máxima, sua mera detecção não implica necessariamente em infecção grave ou fatal.
A distinção entre colonização e infecção ativa é crucial. No caso de Campinas, o hospital confirmou a morte de dois pacientes que portavam a KPC, mas enfatizou que a causa do óbito não foi atribuída diretamente à superbactéria. Este cenário sublinha a complexidade no manejo e na interpretação dos achados laboratoriais, onde a presença do microrganismo requer cautela, mas não sempre se traduz em doença clinicamente manifesta.
Sintomas, Transmissão e Estratégias de Prevenção
As infecções causadas pela KPC tendem a acometer pacientes com o sistema imunológico debilitado, principalmente aqueles internados em Unidades de Terapia Intensiva (UTIs). Quando ativa, a superbactéria pode levar a infecções severas, como a sepse (infecção de corrente sanguínea), pneumonia, infecções do trato respiratório, infecções de feridas operatórias e, com menor frequência, infecções urinárias.
A transmissão da KPC ocorre majoritariamente por contato direto com fluidos de indivíduos colonizados ou infectados, ou através de equipamentos médicos contaminados, como ventiladores mecânicos, cateteres e sondas. Falhas nos processos de higiene e desinfecção do ambiente hospitalar podem resultar na chamada transmissão cruzada, facilitando a rápida disseminação do agente. A incidência de infecções fora do ambiente hospitalar, contudo, é consideravelmente baixa.
A prevenção é a ferramenta mais eficaz para conter a disseminação da KPC. Para a população em geral, a recomendação é a higiene rigorosa das mãos com água e sabão ou álcool gel, especialmente após contato com outras pessoas ou superfícies. Para os profissionais de saúde, é imperativo obedecer estritamente às normas específicas de higiene e segurança, incluindo a correta higienização das mãos, o uso adequado de EPIs e a desinfecção criteriosa de superfícies e equipamentos, garantindo assim a proteção dos pacientes e da própria equipe.
Conclusão: Vigilância Contínua e Compromisso com a Saúde Pública
A detecção da superbactéria KPC no Hospital Estadual de Sumaré, embora em pacientes colonizados e sem infecção ativa, reforça a necessidade de vigilância contínua e a manutenção de protocolos de biossegurança exemplares em todas as instituições de saúde. A capacidade dessas bactérias de se tornarem resistentes aos antibióticos representa um dos maiores desafios da medicina moderna, exigindo um esforço conjunto de profissionais, gestores hospitalares e da população para mitigar os riscos.
A transparência na comunicação e a adoção de medidas preventivas eficazes, como as implementadas em Sumaré, são fundamentais para proteger a saúde dos pacientes e conter a proliferação desses microrganismos. A conscientização sobre a importância da higiene e o uso racional de antibióticos são passos cruciais na luta global contra a resistência antimicrobiana, garantindo um ambiente hospitalar mais seguro para todos.
Fonte: https://g1.globo.com
 Jornal Imprensa Regional O Jornal Imprensa Regional é uma publicação dedicada a fornecer notícias e informações relevantes para a nossa comunidade local. Com um compromisso firme com o jornalismo ético e de qualidade, cobrimos uma ampla gama de tópicos, incluindo:
Jornal Imprensa Regional O Jornal Imprensa Regional é uma publicação dedicada a fornecer notícias e informações relevantes para a nossa comunidade local. Com um compromisso firme com o jornalismo ético e de qualidade, cobrimos uma ampla gama de tópicos, incluindo: